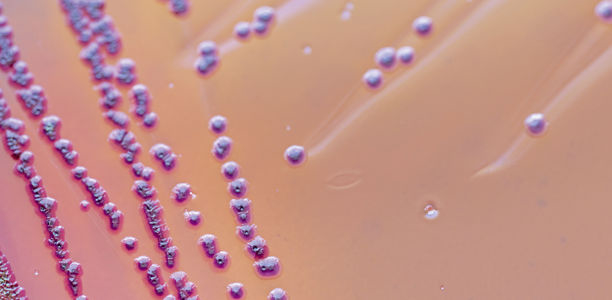
Bild zu Multiresistente Erreger - Infektionspräventives Vorgehen bei MRGN-Nachweis im Kindesalter

Werden multiresistente Erreger bei einem Kind nachgewiesen, bietet die Basishygiene die beste Infektionsprävention. Was hat es damit im Einzelnen auf sich? Und was ist z. B. bei Besuchen in der kinderärztlichen Praxis zu beachten?
Dieser Beitrag steht nur registrierten Benutzern mit Berufsverifizierung zur Verfügung. Jetzt anmelden.Multiresistente Erreger
Infektionspräventives Vorgehen bei MRGN-Nachweis im Kindesalter
© fotolia - sinhyu
© fotolia - sinhyu
